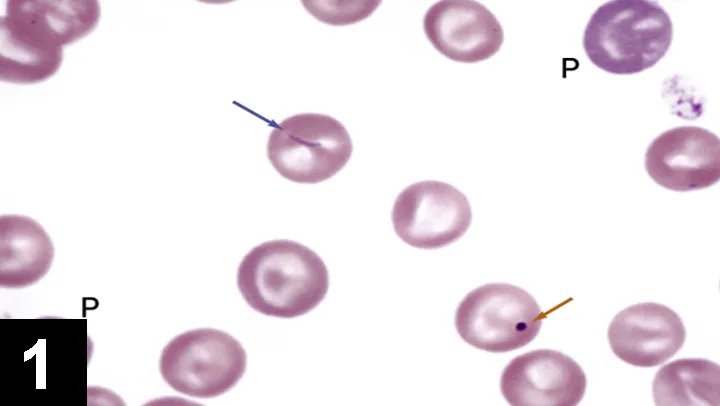
Featured Image

An 11-year-old spayed female mixed-breed dog presented with a 2-week history of lethargy and weakness that progressively worsened until she began to tremble and was unable to stand.
History. The dog was examined 2 months previously due to listlessness and a shuffling gait. A CBC revealed normocytic, normochromic anemia (hematocrit 20%) with mild anisocytosis and mild acanthocytosis; mild thrombocytopenia (152 × 103/mcL); and lymphopenia (0.3 × 103/mcL). An enlarged spleen was noted on palpation and a presumptive diagnosis of hemangiosarcoma was made.
Related Article: Anemia in a Cat— Can You Identify Why?
Splenectomy was performed 3 weeks later and a whole blood transfusion was given. A splenic hematoma was diagnosed by histologic examination of the excised spleen. Hematocrit was 42% following the splenectomy and transfusion. Recovery from surgery was uneventful.
Physical Examination. The mucous membranes were very pale and the pulse was rapid. Rectal temperature was 103° F.
Laboratory Evaluation. A CBC showed macrocytic (high MCV), hypochromic (low MCHC) anemia with absolute reticulocytosis (Table). The plasma appeared colorless when blood was centrifuged in a microhematocrit tube. A platelet count was not done, but the platelet numbers appeared to be increased on the stained blood film.
Erythrocyte morphologic abnormalities included moderate anisocytosis, moderate polychromasia, and frequent Howell-Jolly bodies (Figure 1). Additionally, basophilic structures were associated with some erythrocytes (Figures 1 and 2). A slight left shift, lymphopenia, and metarubricytosis (nucleated erythrocytes) were also present. The direct Coombs (antiglobulin) test was positive when performed at 37° C.
Figure 1: Two polychromatophilic erythrocytes (P), a Howell-Jolly body in an erythrocyte (orange arrow), and a beaded basophilic structure associated with an erythrocyte (blue arrow) Wright-Giemsa stain; original magnification, 2000×

Figure 2: Beaded basophilic structures associated with 3 erythrocytes Wright-Giemsa stain; original magnification, 2500×**
Ask Yourself...**
Is the anemia regenerative or nonregenerative?
What is the general mechanism responsible for producing the anemia?
What are the basophilic structures associated with the erythrocytes?
Diagnosis: Hemolytic anemia caused by Mycoplasma haemocanis infection
Related Article: Coombs Testing: A Diagnostic Step for Anemic Cats
Cytology & Interpretation. The anemia is considered to be regenerative based on the absolute reticulocyte count; however, heavily parasitized erythrocytes might appear as reticulocytes in the stain, falsely increasing the reticulocyte count. Nevertheless, since canine reticulocytes appear as polychromatophilic erythrocytes in routinely stained blood films, the increased polychromasia confirms that reticulocytosis is truly present.1 In addition, metarubricytosis, which is present in this case, often accompanies regenerative anemia in dogs (Figure 3).
Figure 3: A polychromatophilic erythrocyte (P), nucleated erythrocyte (N), and chain of M haemocanis organisms on an erythrocyte (arrow) Wright-Giemsa stain; original magnification, 2000×

Decreased erythrocyte production can be ruled out as a cause of anemia based on the reticulocytosis present. The absolute reticulocytosis indicates that anemia is a result of either erythrocyte destruction (hemolytic anemia) or hemorrhage. The macrocytic hypochromic erythrocyte indices result from the production and release of large reticulocytes that have not yet completed hemoglobin synthesis.
The marked reticulocytosis and macrocytosis suggest that, in this case, the anemia is a result of increased erythrocyte destruction.2 Hemorrhage results in a loss of iron, which tends to limit the magnitude of regenerative response. In contrast, serum iron values are generally increased with hemolytic anemia because iron is readily released from macrophages that have phagocytized erythrocytes and degraded their hemoglobin.2
The basophilic structures on the outside of erythrocytes are consistent with Mycoplasma haemocanis organisms, which often form chains that appear filamentous.1 PCR and sequencing of the 16S rRNA gene were not performed in this case, so the possibility of another hemotrophic mycoplasma (trivial name, hemoplasma) infection cannot be ruled out.
Discussion. Based on genetic analysis, Haemobartonella canis has been reclassified as Mycoplasma haemocanis.3 This hemoplasma commonly appears as filamentous chains extending across the surface of affected canine erythrocytes; however, individual organisms may also appear as small dots, rods, and rings. Chains form as organisms replicate in grooves or deep infolding on the surface of erythrocytes (Figure 4).
Figure 4: Chains of M haemocanis organisms on erythrocytes. Chains form as organisms replicate in grooves (arrow) on the surface of erythrocytes Wright-Giemsa stain; original magnification, 3000×

The sequence of the 16S rRNA gene of M haemocanis is remarkably similar (99% homology) to that of M haemofelis (formerly Haemobartonella felis), suggesting that these agents might be different strains of the same organism.3 In contrast to cats with M haemofelis infection, in dogs splenectomy is generally required before clinically significant hemotrophic mycoplasmosis occurs. However, cases have been described in nonsplenectomized dogs with concurrent Ehrlichia, Babesia, bacterial, and viral infections; in those receiving immunosuppressive drug therapy; and also in those with splenic pathology. Rare cases have occurred in spleen-intact dogs in which no evidence for immunosuppression was found.
Transmission of M haemocanis has been demonstrated experimentally by the brown dog tick (Rhipicephalus sanguineus). Iatrogenic transmission of M haemocanis by blood transfusion from clinically normal carrier dogs can also occur.3 Chronically infected carrier animals may not be anemic or have sufficient numbers of organisms present in the blood to be recognized on routine blood film examination. A PCR-based test can be used to screen blood donors for latent infections, but this was not done in this case.
This dog might have had a latent infection with this hemoplasma, causing hemolytic anemia to develop following splenectomy. Alternatively, the dog might have been infected with the hemoplasma by the blood transfusion.
Diagnostic Findings. Typically, peripheral blood evidence of a regenerative bone marrow response to anemia is present due to the time elapsed between development of anemia and initial recognition of the disease by a veterinarian. Hematologic findings include reticulocytosis with increased polychromasia, anisocytosis, and metarubricytosis. Macrocytosis takes more time to develop than reticulocytosis, indicating that this animal was probably anemic for several weeks.
No consistent leukogram abnormalities are recognized in canine hemotrophic mycoplasmosis.3 As in this case, neither icteric plasma nor hemoglobinemia is generally recognized in dogs with this disease. Substantial bilirubinuria may occur, but urinalysis was not performed in this dog. In addition, the direct Coombs test may be positive in dogs with hemotrophic mycoplasmosis. Researchers have postulated that the attachment of organisms to erythrocytes either exposes hidden erythrocyte antigens or results in altered erythrocyte antigens, to which the host responds by producing antierythrocyte antibodies.3
Treatment. Blood transfusions should be administered when the anemia is considered life-threatening. Orally administered tetracycline antibiotic therapy (such as doxycycline 5 mg/kg Q 12 H for 3 weeks) is efficacious. Animals that recover from hemotrophic mycoplasmosis may have latent infections even though they are no longer anemic.3
Did You Answer?
The anemia is regenerative
The anemia most likely resulted from increased erythrocyte destruction (hemolytic anemia) or increased erythrocyte phagocytosis
The basophilic structures on the erythrocytes are presumably Mycoplasma haemocanis organisms